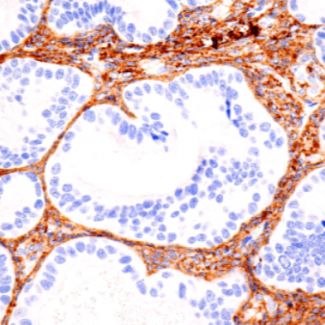
17羟孕酮抗体(17OH PROG)

Screen Quest 免洗钾离子通道检测试剂盒
Screen Quest 免洗钾离子通道检测试剂盒 货号 36550 存储条件 Multiple 规格 1 Plate Ex (nm) 495 Em (nm) 516 分子量 溶剂 简要概述 钾(K+)离子通道在调节基本生物过程(包括心率,激素和神经递质分泌,水和电解质平衡)中起重
品牌:AAT Bioquest货号:36550
询价

苯甲酰乌头原碱 466-24-0 Benzoylaconitine 优势现货
苯甲酰乌头原碱 466-24-0 Benzoylaconitine 优势现货 品牌:辰光生物 英文名称: Benzoylaconine 纯度:HPLC98% CAS 号: 466-24-0 分子量:603.70 分子式:C32H45NO10 分类; 生物碱 产品编号:HH0010
品牌:辰光生物货号:HH001006
询价

骨髓输液通路用钻EZ-IO G3 Power Driver
公司的EZ-IO耗材一次性使用穿刺针套件,为成人和儿童患者于紧急,急迫或医疗必须情况下通路无法获得或获得困难时,在胫骨近端,胫骨远端和肱骨头(肱骨近端)以及儿童患者的股骨远端提供骨髓输液通路。留置时间为24小时。 可以输入哪些药? 任何可以安全输入中心静脉导管的药物均可 输入药物的
品牌:EZ-IO货号:352523235235
询价

德国GKE BD模拟测试系统
Bowie-Dick-测试是功能测试(所谓的类型测试,而不是无菌测试),它主要用于检测预真空蒸汽灭菌器的空气清除以及蒸汽穿透能力。按照EN285要求测试的时候要求灭菌器空载,这是一个每日必须要进行的测试,它不能替代后面每锅灭菌的常规监测。 EN 285 以及AAMI/ANSI S
品牌:其他货号:37287484688
询价

SMA检测试剂--人运动神经元存活基因1(SMN1)检测试剂盒
人运动神经元存活基因 1(SMN1) 检测试剂盒(PCR-熔解曲线法) 检测靶标 定性检测人基因组 DNA 中第 7 外显子和(或)第 8 外显子运动神经元存活基因 SMN1 基因的拷贝数。 检测限 10 ng/μL 精密度 1 份 7、8 号外显子 SMN1 基因均为单拷贝的精
品牌:TIANLONG天隆科技货号:SMN1
17羟孕酮抗体(17OH PROG)
英文名称:17OH PROG,17α-HYDROXYPROGESTERONE Rabbit Polyclonal Antibody,Anti-17αOH Progesterone C-3,Polyclonal Anti-17αOH Progesterone C-3,Antibod
品牌:Pantex货号:115, 47AC, 5895B, 5895D
询价

二肉豆蔻酰基磷脂酰丝氨酸DMPS| 14:0 PS|105405-50-3
二肉豆蔻酰基磷脂酰丝氨酸DMPS| 14:0 PS|105405-50-3 英文名称:DMPS,Dimyristoyl Phosphatidylserine 中文名称:二肉豆蔻酰基磷脂酰丝氨酸 别 名:1,2-dimyristoyl-sn-glycero-3-phospho-L-
品牌:新研博美货号:105405-50-3
询价

西安兰州西宁银川实验室超纯水机
实验室用超纯水机概述 实验室用超纯水对水质大都要求比较高,根据不同的应用场合又可分为三个级别用水:一级用水,电阻要求大于10MΩ(电导率低于0.1us/cm),主要用于有严格要求的分析试验,包括对颗粒有要求的试验。如高压液相色谱分析用水。一级水常用二级水经过石英设备蒸馏或反渗透及
品牌:华科货号:hugke002
询价

醋酸棉酚
本单位从棉籽粕及粗棉籽油里面分离生产醋酸棉酚。 常年给国内外科研院所,新药研发机构供应。 产品纯度高效液相色谱法 98%以上。 常年生产,价格合理,能稳定供货。欢迎选购。
品牌:#货号:BH0008
询价

供载药多层脂质体
该产品已形成硫酸铵梯度,供主动载药使用。 DSPC/CHOL/MPEG-DSPE脂质体带有铵梯度是载药脂质体的选择,可以选择弱碱性化合物,可实现较高包封率,稳定。在主动载药过程中,需要温度控制在DSPC的相变温度55度以上。如有必要,可采用葡聚糖凝胶柱、超速离心或超滤法除去未包封
品牌:lipos货号:F20203A
询价

DiR细胞膜近红外荧光染料
DiR细胞膜近红外荧光染料 产品编号:DR-05、 DR-10 规格: 5mg、10mg 储存条件: -20℃ 避光保存,有效期一年。。 λEx/λ Em(MeOH) = 748/780 nm 分子式:C63H101IN2 分子量:1013.4 产品介绍 DiR 是一个亲脂性、近
品牌:ZETA LIFE货号:DR-05、 DR-10
询价

mPEG-FA 甲氧基PEG-FA 叶酸-聚乙二醇
mPEG-FA MW:10000 mPEG-FA 甲氧基PEG-FA FA聚乙二醇 中文名称:甲氧基聚乙二醇叶酸 英文名称:Methoxy PEG Folate 分子量: 2K ,5K,10K,20K,30K(黄色粉末) 商品型号:PS1-FA 端基取代率:≥90% 原料分散系数
品牌:西安齐岳创科生物货号:q-y-0006
询价

123847-85-8
123847-85-8 中文名称:N,N'-二苯基-N,N'-(1-萘基)-1,1'-4,4'-二胺 英文名称:N,N'-Bis(naphthalen-1-yl)-N,N'-bis(phenyl)benzidine 英文简称:NPB 颜色:Pale yellow CAS: 123
品牌:齐岳生物货号:018282811
询价

GC Fast SYBR Green qPCR Master Mix UDG
【产品组成】 Component A402-01 (500rxn/20 μl reaction) A402-02 (2500rxn/20 μl reaction) 2×GC Fast SYBR Green qPCR Master Mix UDG a 4×1.25 ml 5×A40
品牌:基恩科货号:A402
询价

AX70/AX71-SSI-P防爆光电绝对值编码器
AX70/AX71-SSI-P防爆光电绝对值编码器|德国Hengstler(亨士乐) 符合气体和粉尘的 ATEX 防爆认证 ATEX认证:防油污,防尘爆 与ACURO拥有相同的电子性能 保护等级高达IP67 直径仅70mm 稳健的设计 可以提供不锈钢产品 可加不锈钢保护壳(AX7
品牌:Hengstler编码器货号:AX70/AX71
询价

葛根素98%
【产品名称】葛根素 【产品别名】葛根黄酮;8-beta-D-葡萄吡喃糖-4',7-二羟基异黄酮 【英文名称】puerarin;Daidzeine 【产品来源】豆科植物野葛Pueraria lobata (Willd.)Ohwi的干燥根。 【 CAS 号 】3681-99-0 【产
品牌:西安汇林生物科技有限公司货号:HL202202010
询价

辅料羟丙基倍他环糊精
辅料羟丙基倍他环糊精药用级羟丙基倍他环糊精 药用辅料 有批件 资质齐全 [128446-35-5] 本品为倍他环糊精与1,2-环氧丙烷的醚化物。按无水物计算,含羟丙氧基(-OCH2CHOHCH3)应为19.6%~26.3%. 【性状】 本品为白色或类白色的无定形或结晶性粉末;无臭
品牌:晋湘药用辅料货号:JX003
询价

4'-氨甲基-5-羧基荧光素
陕西金杰森茂生物科技有限公司现货及定制合成,包装规格:1g,5g,10g等,具体规格及价格请咨询客服,因化学品的规格繁多,产品的具体规格含量以及对应的价格以客服具体报价为准;备注:我公司产品仅供科研使用,不得用于人体。
品牌:金杰森茂货号:BJ10044
询价

牛蒡子苷元
中文名称:牛蒡子苷元 英文名称:Arctigenin CAS号:7770-78-7 分子式:C21H24O6 分子量:372.417 纯度:HPLC≥98% 包装:20mg~1g 棕色玻璃瓶 外观性状:白色粉末 检测方法:高效液相(HPLC)质谱(Mass) 核磁(NMR) 植物
品牌:点开生物货号:DK7770-78-7
询价

彩超探头_B超探头GE 10L探头价格
质量体系标准实施管理,严把技术关、质量关、检验关,为医院提供无忧的影像设备售后服务。 公司本着“以人为本”的精神,追求维修技术更稳定、更先进,为医院及合作伙伴创造最大价值。我们愿用聪颖的智慧,务实的工作作风,竭诚提供优质高性价比的维修服务,致力于中国的医疗影像设备售后服务! 我们的
品牌:GE货号:ab01762
询价











